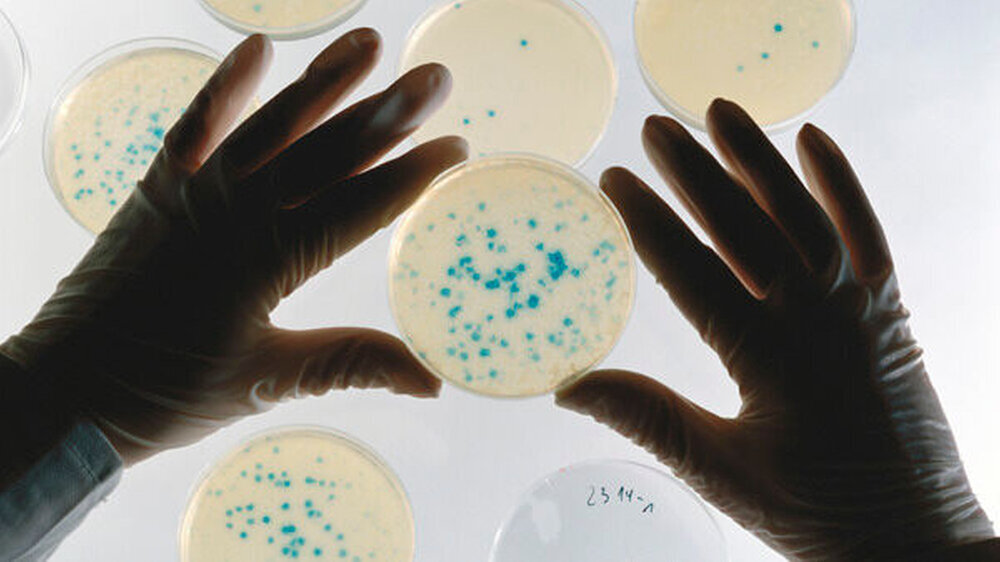

Bahr pocht auf schnellere Meldepflicht bei Infektionskrankheiten
"Der aktuelle Ausbruch zeigt uns, wie schnell solche Situationen auftreten können und wie wichtig es ist, dass die zuständigen Stellen in den Ländern und beim Bund gut vorbereitet sind", sagte Der FDP-Politiker den Dortmunder "Ruhr Nachrichten" (Mittwoch).
Die Pläne über verkürzte Meldefristen bei Infektionskrankheiten liegen derzeit im Vermittlungsausschuss von Bundestag und Bundesrat. Hintergrund ist ein Kostenstreit zwischen Bund und Länder über die Infektionsvorsorge an Flughäfen und Häfen.Der Minister warf den Ländern eine Blockadehaltung vor.
Die Regelungen, die die Bundesregierung als Konsequenz aus dem EHEC-Ausbruch vom Mai/Juni 2011 auf den Weg gebracht habe, "können dadurch noch nicht umgesetzt werden". Nach der vom Bundestag beschlossenen Regelung müssten Gesundheitsämter künftig den Ausbruch schwerer Infektionskrankheiten spätestens am folgenden Arbeitstag an das Robert-Koch-Institut in Berlin melden. Bisher waren wöchentliche Meldungen vorgesehen.